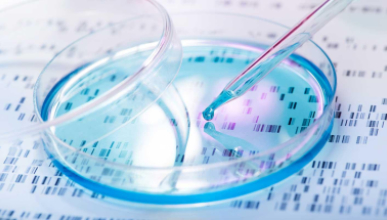
A petri dish and a pipette are shown with a blue liquid

When you study the liberal arts in Los Angeles, your opportunities for academic exploration and hands-on learning are endless.
Choosing majors and minors at Oxy
Occidental’s undergraduate programs include 45 majors and minors across the arts, humanities, and sciences. There are also countless opportunities for independent research, internships, and other experiential learning. Don’t want to limit yourself to one area? You won’t have to—interdisciplinary majors, self-designed courses of study and majors with multiple emphases make your academic journey at Oxy uniquely your own.
Other pathways, programs, and exploration guides
Oxy also offers pre-law and pre-health
What do our students say?
If you want to hear about our various programs direct from the source, check out these Meet Our Majors profiles.